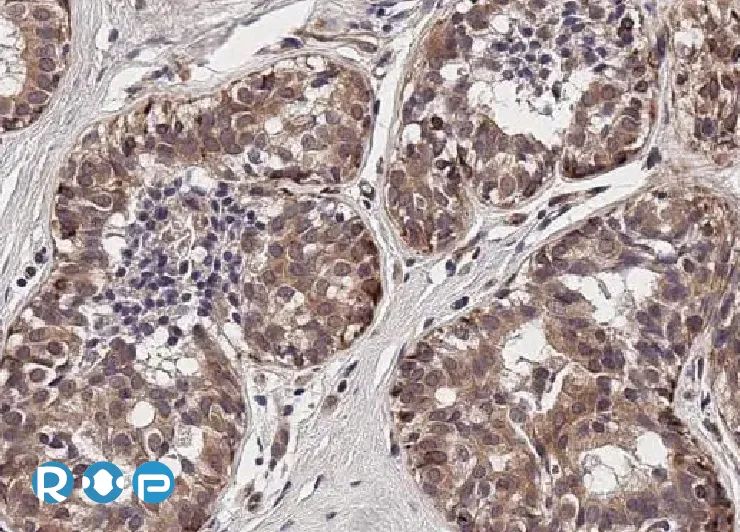
图片

推荐产品
公司新闻/正文
GeneTex新推出重组单抗TIGIT
277 人阅读发布时间:2024-09-11 13:56

TIGIT是一种免疫检查点受体,主要在T细胞和自然杀伤(NK)细胞上表达,TIGIT与其配体的结合可抑制T细胞和NK细胞活化,从而抑制增殖和细胞因子产生,这种调节功能使 TIGIT成为下一代免疫检查点抑制剂的重要关注点。
GeneTex 新推出针对TIGIT的兔重组单克隆抗体,这些抗体已在WB和IHC应用中得到验证。重要的是,我们提供TIGIT抗体 [HMV322] HistoMAX™ (GTX639946)和TIGIT抗体 [HMV323] HistoMAXTM (GTX639947),它们已在正常组织和肿瘤组织中大规模验证IHC。
欢迎随时探索我们的癌症免疫检查点和HistoMAX™ IHC优化抗体。请参阅这些产品的完整列表,如需更多信息,请访问www.genetex.com。
精选产品

 |
TIGIT antibody [HL2655] (GTX639114)
|
TIGIT antibody [HL2657] (GTX639116)
 |
TIGIT antibody [HMV322] HistoMAX™ (GTX639946)
 |
PD-L1 antibody [HL1041] (GTX635975)
 |
PD-L1 antibody [H302] HistoMAX™ (GTX639925)
|
|
CTLA4 antibody [HL2732] (GTX639560)
|
|
CTLA4 antibody [MSVA-152R] HistoMAX™ (GTX04439)
小冊 - HistoMAX™ IHC-Optimized Antibodies
|
|
更多详情请联系 欣博盛生物科技
全国服务热线:4006-800-892
邮箱:market@neobioscience.com
Wechat: 13129540117
深圳:0755-26755892
北京:010-88594029
上海:021-34613729
广州:020-87615159










